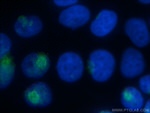
MCFD2 Antibody in Immunocytochemistry (ICC/IF)

Search
Proteintech
MCFD2 Polyclonal Antibody
{{$productOrderCtrl.translations['antibody.pdp.commerceCard.promotion.promotions']}}
{{$productOrderCtrl.translations['antibody.pdp.commerceCard.promotion.viewpromo']}}
{{$productOrderCtrl.translations['antibody.pdp.commerceCard.promotion.promocode']}}: {{promo.promoCode}} {{promo.promoTitle}} {{promo.promoDescription}}. {{$productOrderCtrl.translations['antibody.pdp.commerceCard.promotion.learnmore']}}
产品信息
13068-1-AP
种属反应
宿主/亚型
分类
类型
抗原
偶联物
形式
浓度
规格
纯化类型
保存液
内含物
保存条件
运输条件
产品详细信息
Immunogen sequence: MTMRSLLRT PFLCGLLWAF CAPGARAEEP AASFSQPGSM GLDKNTVHDQ EHIMEHLEGV INKPEAEMSP QELQLHYFKM HDYDGNNLLD GLELSTAITH VHKEEGSEQA PLMSEDELIN IIDGVLRDDD KNNDGYIDYA EFAKSLQ (1-146 aa encoded by BC040357)
靶标信息
Multiple coagulation factor deficiency protein 2 (MCFD2) is localized in the endoplasmic reticulum-Golgi intermediate compartment (ERGIC) through a direct, calcium-dependent interaction with LMAN1. The MCFD2-LMAN1 complex forms a specific cargo receptor for the transport of selected proteins from the endoplasmic reticulum to the Golgi apparatus. Mutations in the MCFD2 gene may cause of factor V and factor VIII combined deficiency (F5F8D). F5F8D is an autosomal recessive human bleeding disorder characterized by the reduction of both clotting proteins.
仅用于科研。不用于诊断过程。未经明确授权不得转售。
篇参考文献 (0)
生物信息学
蛋白别名: EF-hand protein; Multiple coagulation factor deficiency protein 2; Multiple coagulation factor deficiency protein 2 homolog; neural stem cell derived neuronal survival protein; Neural stem cell-derived neuronal survival protein; stem cell derived neuronal survival protein; unnamed protein product
基因别名: 1810021C21Rik; F5F8D; F5F8D2; LMAN1IP; MCFD2; SDNSF
UniProt ID: (Human) Q8NI22, (Mouse) Q8K5B2, (Rat) Q8K5B3
Entrez Gene ID: (Human) 90411, (Mouse) 193813, (Rat) 246117